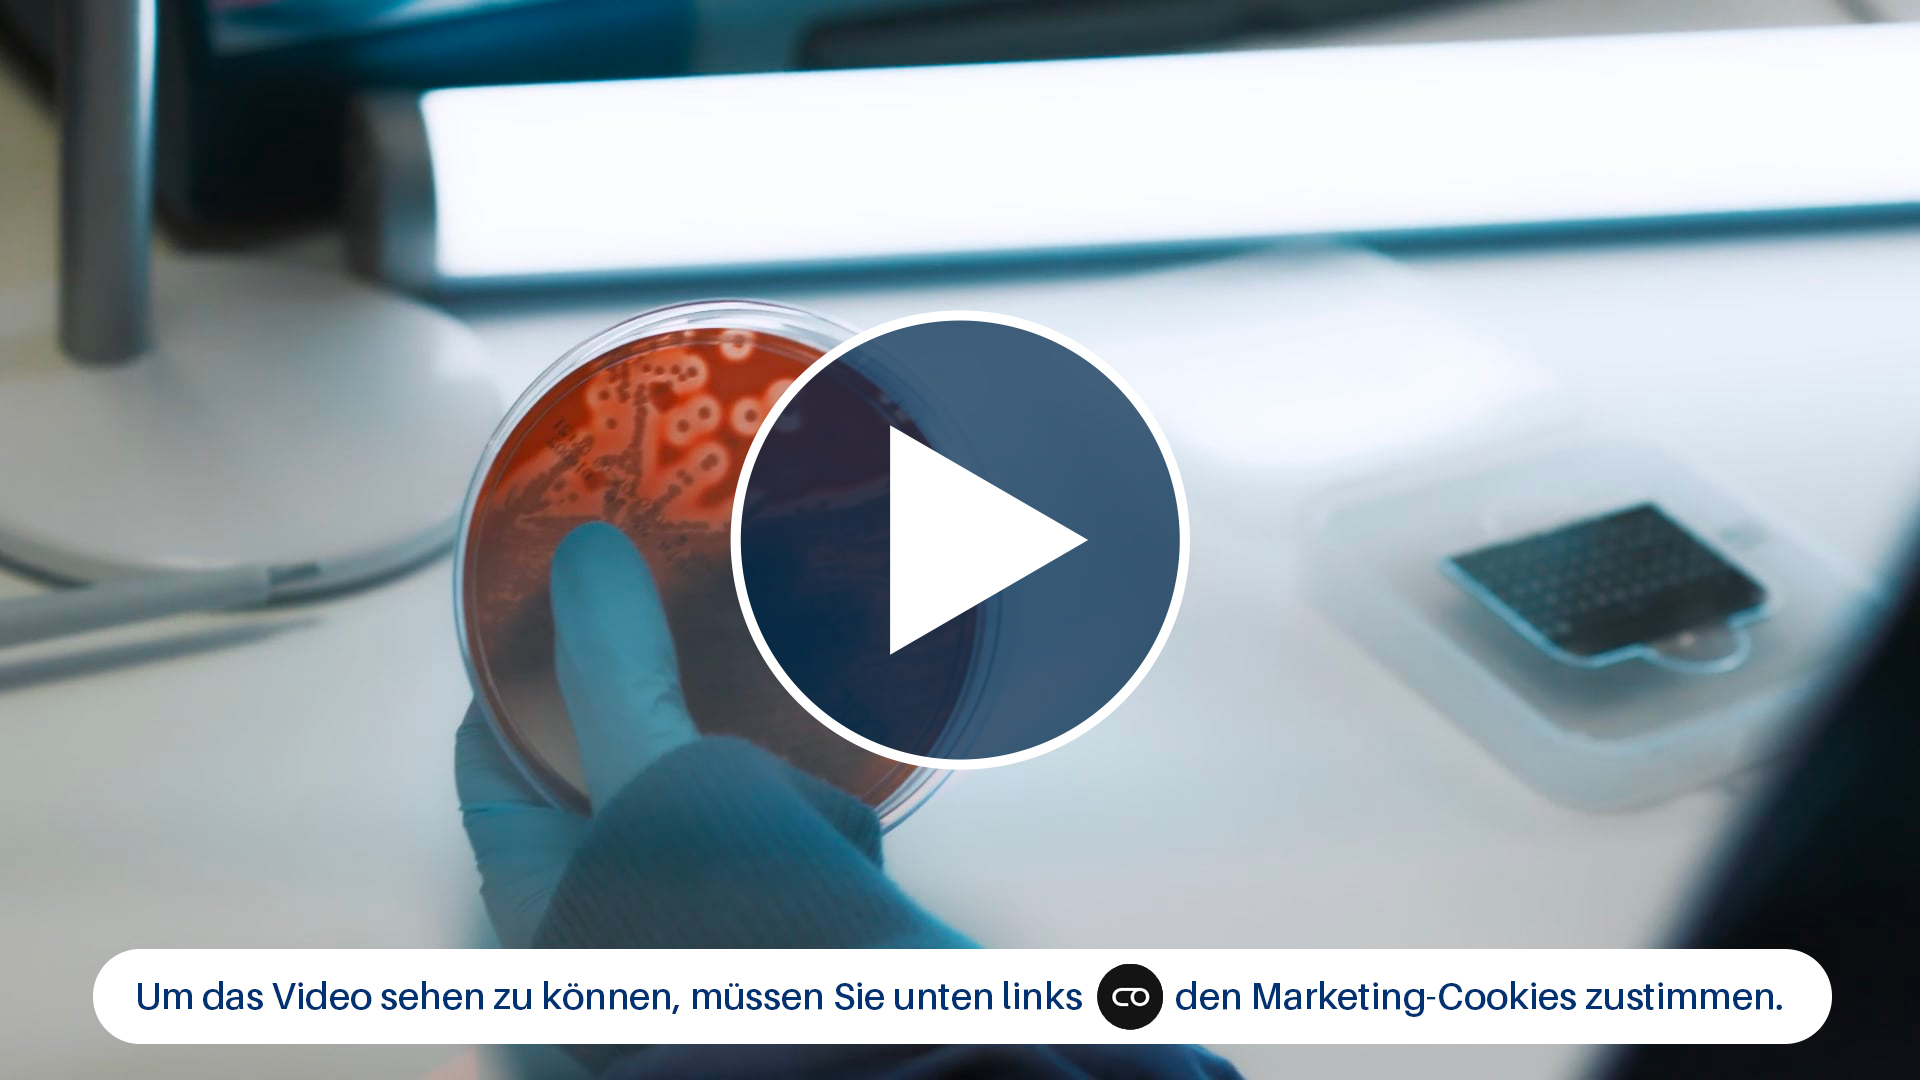
Vorschaubild des Videos mit dem Hinweis, dass man den Marketing-Cookies zustimmen muss, um es abspielen zu können

Über uns
"Wir sind ein Verbund von medizinischen Laboren, die in ihrer jeweiligen Region tief verankert sind. Administration und Wissensaustausch haben wir zentral organisiert, sodass wir arbeitsteilig und mit flacher Hierarchie unseren Versorgungsauftrag bestmöglich erfüllen können. Unsere Einsender profitieren davon, dass wir sämtliche labordiagnostischen Dienstleistungen aus einer Hand bieten, einschließlich Genetik und Infektionsprävention. Immer dabei: Beratung in allen Phasen unserer Leistungen."
Dies sind unsere Kunden:
- Niedergelassene Ärzte aller Fachrichtungen,
- Vorsorgebewusste Verbraucher,
- Krankenhäuser aller Größenordnungen,
- Öffentliche Auftraggeber und Hochschul-Institute,
- Arbeits- und Betriebsmediziner,
- Tierärzte und Tierkliniken,
- Internationale Auftraggeber.
Lernen Sie Bioscientia kennen
Rund 3.000 Mitarbeiter an 25 Standorten bearbeiten rund 100.000 Patientenproben pro Tag. Neben der qualitätsgesicherten Analytik legen wir viel Wert auf kundennahe Services, mit denen wir unsere Partner begeistern möchten. Seit 2007 gehören wir zur Sonic Healthcare Germany und sind gestaltender Teil eines internationalen Netzwerks aus ärztlich geleiteten Laboren.
"Reden Sie mit uns über Werte, Ziele, Zukunft."
Laura Ranzenberger
Leitung Marketing und Kommunikation
Tel.: +49 6132 781-644
laura.ranzenberger@bioscientia.de